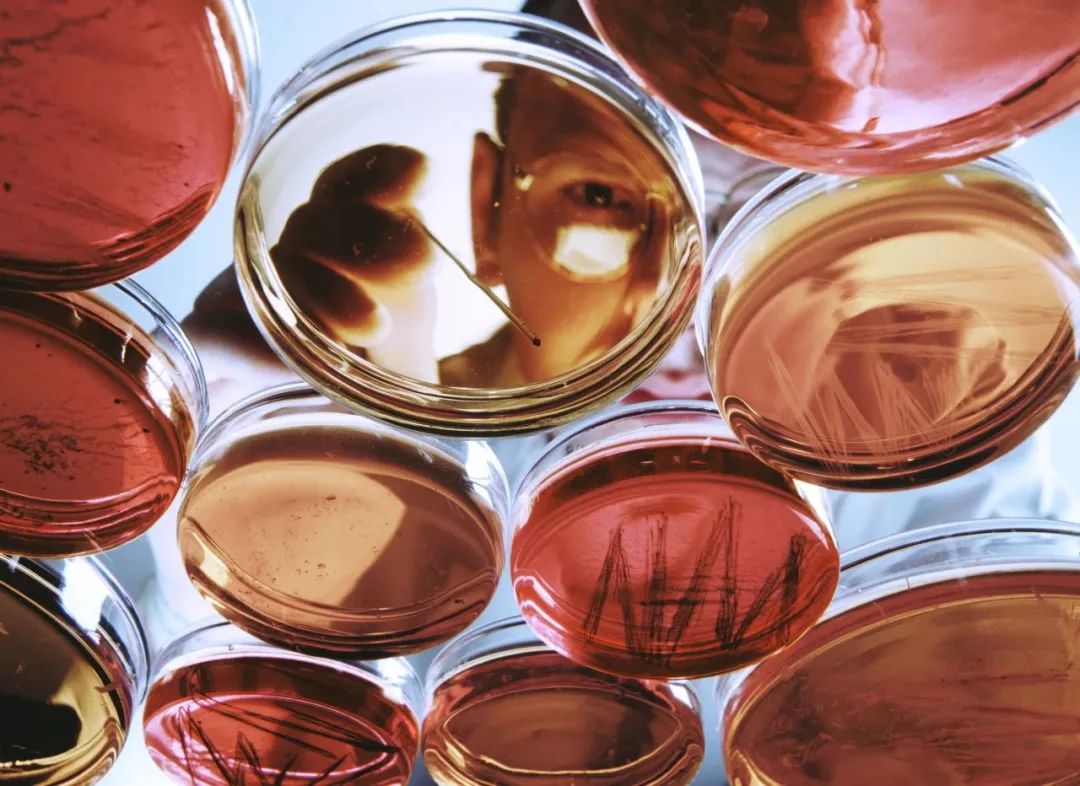

随着全球医药市场快速发展、国家政策扶持以及药物研发水平的逐步提升,中国注册的临床试验数量呈现逐年增加的趋势,已成为全球第二大医药消费市场。近些年药物临床试验的项目增多,而临床试验过程中的风险巨大,所以伴随临床试验的增加,发生临床试验风险事件的可能性也不断增加。《国家药品不良反应检测年度报告(2022)》统计数据显示1,2022年我国药品不良反应监测网络共收到202.3万份药品不良事件报告。1999年至2022年,全国药品不良反应监测网络累计收到《药品不良反应/事件报告表》208.56万份。我国药品不良事件呈逐年上升的趋势,相应的受试者与申办者的纠纷也越来越多。在这种情况下,无论申办方还是受试者,都需要通过有效的第三方保险来降低自身风险。现有的临床试验责任险已经成为了临床试验过程中受试者权益的关键保障, 是申办方分担经济赔偿风险的重要机制,也是医院、机构和伦理委员会避免不必要纠纷的主要手段。从2003年起,我国已将购买药物临床试验保险纳入相关政策法规。
但是近些年,试验终止和延期开展对于生命科学企业造成的影响也逐渐增加。生命科学行业市场咨询公司Evaluate旗下的Vantage发布文章表示2,随着新冠疫情在全球范围内的传播及其带来的影响,生物制药领域投资人必须开始考虑部分正在进行的临床试验延期或者终止的风险。
据Vantage的文章统计2,大约有315项、涉及172,104例受试者的关键性临床试验会受到影响。国内方面,疫情期间《经济观察报》发表的文章显示3,国内逾70%临床试验受疫情影响,或整体将新药上市时间推迟半年。
制药企业方面,由于其研发受到打击,临床开发计划也要向后延期。近年来国内研发火热的各类肿瘤项目则是受影响相对严重的领域。一方面由于肿瘤患者本身免疫力较低,属于感染新冠的高危人群,一旦受试者感染则将直接对相应的临床试验产生不利影响;另一方面,肿瘤药物的临床试验,涉及到生物标志物检查、影像检查、病理检查等多个领域,需要更多地与第三方机构合作,一旦其中一环受到影响,整个临床试验也会相应推迟。
创新药研发周期长、投入高、风险大,要想最终走向成功并非易事。药物研发“九死一生”,因缺乏足够临床活性、未达疗效标准等原因终止或暂停临床试验的情况,不仅仅出现在生物技术公司,在大型制药公司也屡见不鲜。

//
在这样的风险背景下,中怡保险经纪联合太平洋财险,经过全面的市场调研,共同推出临床试验的延期或终止费用补充保险,该险种在整个开发阶段得到中怡保险经纪生命科学团队的专业技术支持及太平洋财险各位领导及核保的大力支持,进一步提升了临床试验责任险的风险覆盖面,为助力生命科学企业的发展提供了更加全面的保险保障,是一次非常大的突破。
中怡保险经纪从2006年成立了生命科学团队,一直是全球超大生物技术公司非常紧密的合作伙伴,拥有一支专业的服务团队,致力于行业的深入研究、风险洞察及分析,能够为客户提供全面、量身定制的一站式风险解决方案。
太平洋财险在生命科学领域拥有丰富的服务经验。产品开发方面,公司产品配套齐全,覆盖上市前和上市后产品全生命周期的风险敞口,为客户提供多方面、多层次的全面保障。团队建设上,随着生命科学保险被列为重点发展的战略型险种,太平洋财险成立了专业化生命科学服务团队。近年来,太平洋财险逐步与再保人加深合作,目前已实现与再保人直接沟通,报价效率显著提升,已形成了能够满足国际多中心临床试验的技术支持、数据支持和再保支持。全球服务网络约230个,几乎可以覆盖所有地区,并开通了绿色理赔通道及时处理理赔,为客户提供全面、专业的保险服务,帮助客户更好地管理和规避风险。
生命科学领域是保险公司近几年非常关注的热点行业,在国家政策扶持的大环境下,如何通过商业保险助力医药企业的创新及发展也成为了保险公司创新的重点方向。
本次中怡保险经纪联合太平洋财险,在已有的临床试验保障的基础上增加了关于临床试验延期或终止的保险保障,可以为企业覆盖由于特定原因引起试验延期或者终止时产生的统计费、临床服务费用、实验相关检查等费用的赔偿,并提供承保保单中载明的约定责任导致临床试验延期或终止的保障。这款新的临床试验责任保险产品还可以帮助企业转移延误和终止风险,保障前期投入的部分经济损失。
该款保险产品为临床试验申办者和企业在临床试验阶段提供了更加全面的保险保障,在保险市场为首创产品,它可以减轻种种原因导致的试验无法如期顺利进行而产生的高额研发费用。我们希望这种保险产品能够被更多的人认识和使用,为临床试验的发展和创新做出更大的贡献,提供更全面的保险保障。
引用来源:
1https://www.cdr-adr.org.cn/
2Evaluate vantage.Clinical trial delays become reality as Covid-19 risk spreads.
3https://baijiahao.baidu.com/s?id=1660323664084902422&wfr=spider&for=pc
如需获取更多信息或有相关需求,敬请联系:
刘尧成
中怡保险经纪生命科学团队负责人
邮箱:porsh.liu@aon-cofco.com.cn
电话:+86 (20) 3816 5963
李欢
中怡保险经纪大型商业风险部总监
邮箱:stephanie.li@aon-cofco.com.cn
电话:+86 (10) 5632 8605
关于中怡保险经纪 2003年,中怡保险经纪有限责任公司(简称“中怡保险经纪”)获中国保险监督管理委员会批准开业。中怡保险经纪是首家获准在中国境内从事保险、再保险经纪和风险管理咨询业务的中外合资保险经纪公司。合资双方分别为提供广泛的风险管理、退休计划及健康福利方案的世界领先的专业服务公司怡安集团(简称“怡安”),以及中国大型企业集团中粮集团有限公司(简称“中粮”)。中怡保险经纪总部位于上海,先后在北京、上海、南京、广州、成都、深圳、杭州和济南设立分公司。如今,中怡保险经纪已经成为一家在风险管理、保险及再保险经纪领域处于领先地位的综合服务提供商,在全国拥有超700名员工。了解更多相关信息,请访问:www.aon-cofco.com.cn
关于怡安集团 怡安集团(纽约证交所股票代码:AON)致力于提升决策质量,在全球范围内通过专业服务,保障人们的安全并丰富他们的生活。怡安在120多个国家和地区为客户提供清晰的建议与专业的解决方案,使他们能够充满信心地做出更优决策,护航业务、实现增长。了解更多相关信息,请访问:www.aon.com
关于中粮集团 中粮(COFCO)集团有限公司是与新中国同龄的中央直属大型国有企业,中国农粮行业领军者,全球布局、全产业链的国际化大粮商。中粮集团以“确保国家粮食安全,把中国人的饭碗牢牢端在自己手中”为己任,致力于打造具有全球竞争力的世界一流粮食企业,构建具有中粮特色的国有资本投资公司。历经70年发展,中粮集团以农粮为核心主业,同时涉及食品、金融、地产领域。作为投资控股企业,中粮集团旗下拥有16家上市公司。了解更新相关信息,请访问:www.cofco.com/cn
